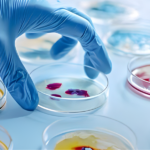
what is the difference between depression and anxiety

what is the difference between depression and anxiety

Most of the people remain confused between depression and anxiety, and even have no idea how to express their issues in front of health professionals for treatment. One should be able to identify basic symptoms, so that health issues may easily be explained to a doctor for proper treatment. A patient of depression usually has symptoms like persistent sadness, loss of interest, and low energy levels.
While anxiety has symptoms like excessive fear, worry or panic. usually patients with anxiety have sleep issues i.e they may have problem in sleep onset, or intermittent insomnia. Moreover they may experience excessive dreaming.
A patient with depression actually lacks the normal perception of pleasure, and has a feeling of ever sadness, that spoils the overall capabilities. In this way a person that was once going well in every field of life, starts to face failures.
Moreover patients with anxiety usually have high heart rates and confusion, consistent high heart rate may damage heart. this high heart rate may be improved by deep breath therapy for 30 or 60 minutes.
Mostly depression and anxiety occur simultaneously, so that most of people have symptoms of both conditions, perhaps it is always required to have an expert opinion from health expert.